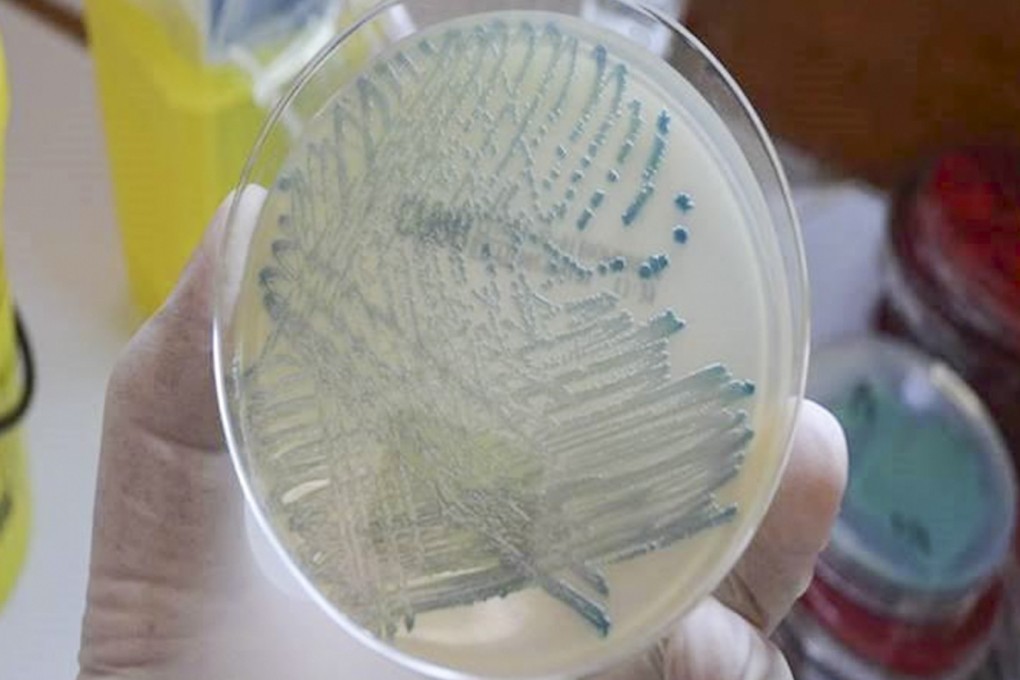
There were 972 cases of carbapenemase-producing enterobacteriaceae (CPE) detected in Hong Kong in 2018. Photo: Hospital Authority

Advertisement
EditorialAction on antibiotics key to superbug fight
- Hospital-acquired infections are a major health concern in city with an ageing population, and more initiatives as well as public education are needed
2-MIN READ2-MIN
It may seem a bit of a stretch to draw a connection between rivers and the struggle to contain the spread of superbug infections in hospitals. After all, major river systems are lifelines for large portions of the world’s population, supplying water and sustaining biodiversity, whereas drug resistance by bacteria is attributed to overuse of antibiotics.
But it has emerged from international research revealed at a conference in Helsinki that hundreds of rivers around the world are awash with dangerously high levels of antibiotics, mainly attributed to run-off of animal waste from agricultural land, where they are used excessively to promote healthy livestock production, as well as human waste and leaks from waste water treatment and drug manufacturing plants.
According to a recent United Nations report, the rise in antibiotic-resistant bacteria is already a global health emergency that could kill 10 million people by 2050.
Advertisement
Watch: How antibiotic resistance works (from 2014)
In Hong Kong, the number of patients diagnosed with the superbug carbapenemase-producing Enterobacteriaceae (CPE) more than doubled last year from 472 to 972, with University of Hong Kong microbiology professor Dr Ho Pak-leung putting most of the blame on overcrowding in public hospitals.
Advertisement
Advertisement
Select Voice
Select Speed
1.00x
